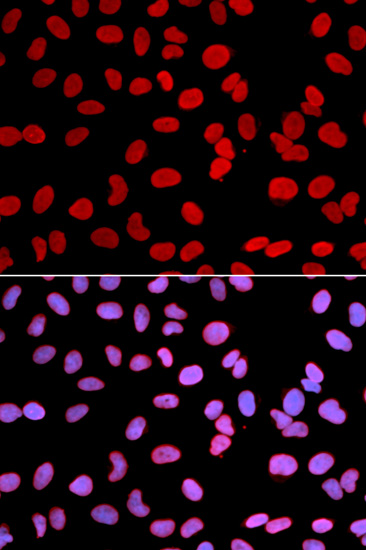
A2534: image 5
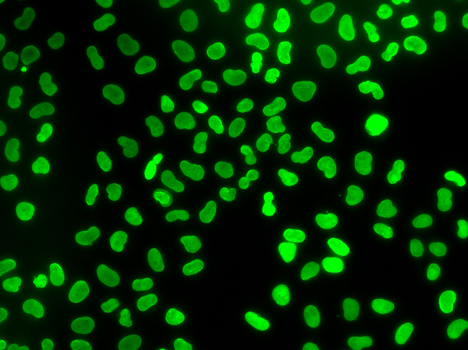
A2534: image 6

For quotations, please use our online quotation form, and you may also contact us by
sales@neoscientific.com
+1-888.733.6849
+1-617.299.7367 (Int’l)
+1-888.733.6849
+1-617.299.7367 (Int’l)
| Reactivity | Human Mouse Rat |
| Tested applications | WB IHC IF |
| Recommended Dilution | WB 1:500 - 1:2000 IHC 1:50 - 1:200 IF 1:50 - 1:200 |
| Calculated MW | 75kDa |
| Observed MW | Refer to Figures |
| Immunogen | Recombinant protein of human TMPO |
| Storage Buffer | Store at -20℃. Avoid freeze / thaw cycles. Buffer: PBS with 0.02% sodium azide, 50% glycerol, pH7.3. |
| Synonym | TP; LAP2; CMD1T; LEMD4; PRO0868; |

Western blot analysis of extracts of various cell lines, using TMPO antibody.

Immunohistochemistry of paraffin-embedded rat lung using TMPO antibody at dilution of 1:100 (x400 lens).

Immunohistochemistry of paraffin-embedded rat brain using TMPO antibody at dilution of 1:100 (x400 lens).

Immunohistochemistry of paraffin-embedded mouse lung using TMPO antibody at dilution of 1:100 (x400 lens).
Immunofluorescence analysis of U2OS cell using TMPO antibody. Blue: DAPI for nuclear staining.
Immunofluorescence analysis of U2OS cell using TMPO antibody.
The protein encoded by this gene resides in the nucleus and may play a role in the assembly of the nuclear lamina, and thus help maintain the structural organization of the nuclear envelope. It may function as a receptor for the attachment of lamin filaments to the inner nuclear membrane. Mutations in this gene are associated with dilated cardiomyopathy. Alternatively spliced transcript variants encoding different isoforms have been noted for this gene.
N/A